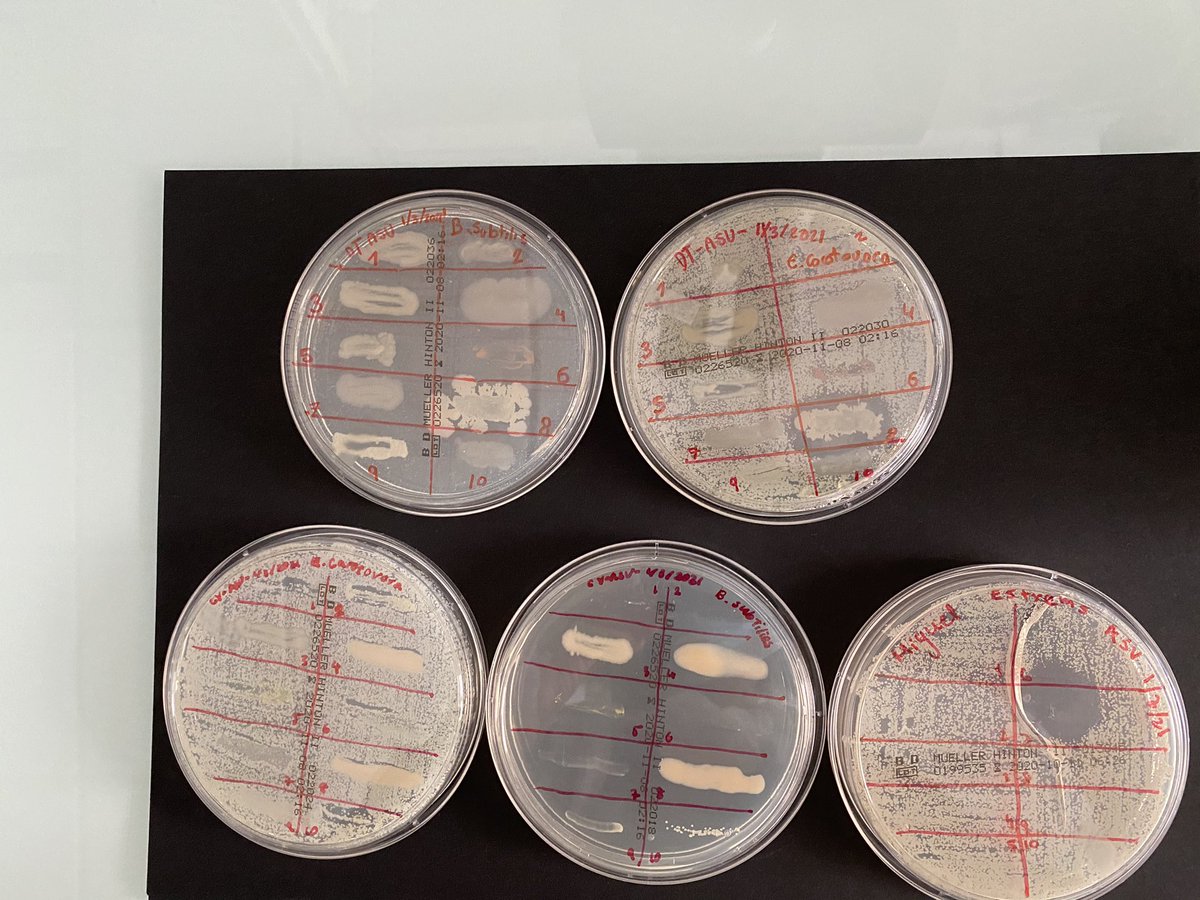
Fin en los coles <a href="/asvtweets/">American School of Valencia</a> #SantaMariadelPuig #SanPedroPascual proyecto de búsqueda de nuevos antibióticos y la concienciación sobre su uso con la colaboración de <a href="/FECYT_Ciencia/">FECYT</a> Nos queda el evento final en <a href="/uchceu/">Universidad CEU UCH</a> seguiremos informando 🎙<a href="/asociacionruvid/">Asociación RUVID</a> <a href="/CienciaUCHCEU/">Ciencia CEU UCH</a> 👉fotos

Congreso Estudiantes
@cieuch
16º Congreso Internacional de Estudiantes #CIEUCH. Fechas: 8-12 de abril
ID: 486389784
http://bit.ly/CIEUCH 08-02-2012 07:33:53
771 Tweet
102 Takipçi
11 Takip Edilen

"Debemos hacer la mejor #comunicación posible al servicio de la #salud" 🎙️📱+🔬🩺 Ana Lavao, estudiante de #Periodismo y #Publicidad en Universidad CEU UCH colabora con sus compañeros de #Salud en SWICEU/MicroMundoCEU, para hacer una comunicación sana. Gracias por tu talento Ana! medios.uchceu.es/actualidad-ceu…


Más de mil jóvenes participan en el reto de SWICEU/MicroMundoCEU sobre el buen uso de los #Antibióticos 💊 de la Universidad CEU UCH. Felicidades a las ganadoras Caitlin Tygart y Lucía Bernat 👏🏼👏🏼👏🏼 ow.ly/QJU550CvR9u


Proyecto SWICEU 4.0: hoy hemos empezado las prácticas 🧫🦠🧪🔬en Universidad CEU UCH con nuestros SWITAs junior y con los senior al pie del cañón 👏👏👏 diluyendo, sembrando e incubando...qué nos encontraremos? Ciencia CEU UCH @Lm97Oscar Caitlin Marie Tygart American School of Valencia Edelweiss School


Fin en los coles American School of Valencia #SantaMariadelPuig #SanPedroPascual proyecto de búsqueda de nuevos antibióticos y la concienciación sobre su uso con la colaboración de FECYT Nos queda el evento final en Universidad CEU UCH seguiremos informando 🎙Asociación RUVID Ciencia CEU UCH 👉fotos

Muy emocionados y agradecidos por el 🥇 recibido en el II Congreso CEU de Innovación Educativa y Docente al proyecto👇👇con la colaboración de FECYT para concienciar e investigar en nuevos antibióticos 💊🧫🔬 Ciencia CEU UCH CEU Universidad CEU UCH #SinCienciaNoHayFuturo









Nuevo reto del equipo SWICEU/MicroMundoCEU para concienciar sobre el buen uso de los #antibióticos frente a las #ResistenciasAntimicrobianas: Hazte #bacthunter🔍📲🦠 Durante la #WAAW2022 nos desafían a capturar 6 imágenes como esta en el campus Universidad CEU UCH Y habrá premio! medios.uchceu.es/actualidad-ceu…


Los estudiantes de Ciencias de la Salud del Universidad CEU UCH organizan un karaoke para concienciar sobre el buen uso de los antibióticos bit.ly/3VosJOZ


Muchas gracias a tod@s l@s bact-hunters🦠👩🏻🔬🧑🏻🔬que habéis venido al Paraninfo Universidad CEU UCH a frenar la pandemia silenciosa. Junt@s concienciamos 📣aprendemos📚e investigamos 🧫🔬🧪sobre el buen uso de los antimicrobianos💊🌏🎶¡Enhorabuena a l@s premiad@s!🏆🏆🏆🏆#bacthunter #WAAW22 #AMR


🎤 Karaoke para concienciar sobre el aumento de las infecciones bacterianas resistentes a los #Antibióticos buff.ly/3V7s3ho 🔘 Estudiantes SWICEU/MicroMundoCEU Universidad CEU UCH han adaptado la letra de canciones conocidas para alertar sobre esta #Pandemia silenciosa.


AMBAIXADORS DE SAPIÈNCIA🤝🏻 Segur que recordeu al següent ambaixador! L'equip SWICEU/MicroMundoCEU investiga i consciència davant un repte de salut global:el desenvolupament de nous antibiòtics i la conscienciació sobre el seu bon ús per a frenar augment de les resistències bacterianes.


El equipo SWICEU Universidad CEU UCH os desea un feliz 2023 con salud, paz, justicia, amor y mucha ciencia. Que os llegue todo aquello, que solo de pensarlo, os llene de felicidad 🧫🦠📚💊🧬🧪🔬Ciencia CEU UCH Asociación RUVID Biólogos de Galicia Micofvlc SEM SEIMC Ciudad Artes Ciencia


SWICEU team Universidad CEU UCH wishes you a happy New Year 2023 with health, peace, justice, love and lots of science. May you get everything that, just thinking about it, fills you with happiness 🧫🧫🦠📚💊🧬🧪🔬 AMR Now Microbiology News Microbiology Society David Walker @CUsuperbugs






